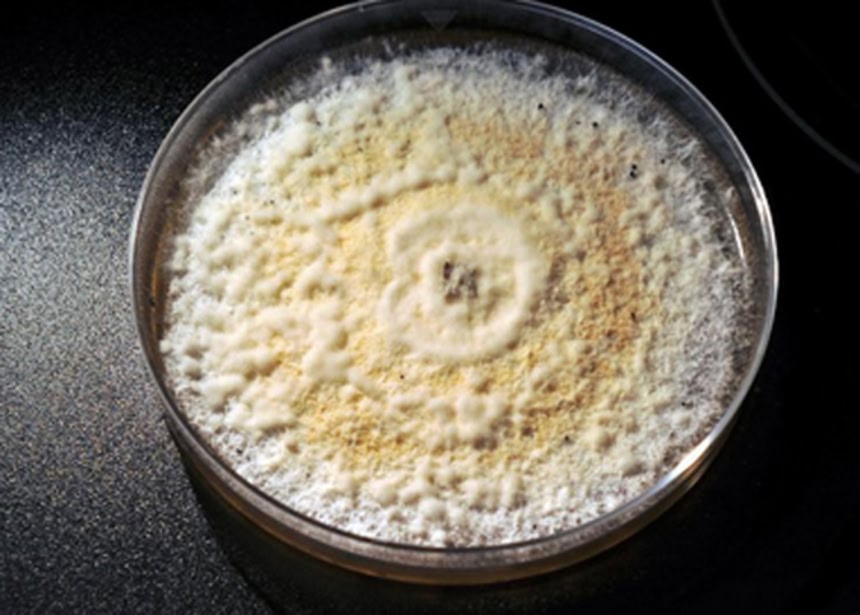

この画像を大きなサイズで見る
この画像を大きなサイズで見る米イエール大学、分子生化学部学生らが、アマゾンに毎年恒例の熱帯雨林の探検調査と称したキノコ狩りを行っていたところ、すごいキノコが狩れたようだ。そのキノコはポリウレタンを炭素に分解する能力を持つという。
source :Yale students discover plastic-eating fungus – Macleans.ca
イエール大学探検隊は、アマゾンにて毎年菌類や植物を採取し研究するという課外授業を行っているが、2008年、学生がグアバの木の一種から採取したキノコにポリウレタンを炭素に分解する能力があることを判明した。
この画像を大きなサイズで見る
この画像を大きなサイズで見るこのキノコの学名は「Pestalotiopsis microspora」。ポリウレタンを分解する能力を持つキノコが発見されたのはこれが初めてだそうだ。
ポリウレタンは、ウレタンフォームや人工皮革、クッション材、塗料、接着剤などに使用されている我々の生活になじみの深いもの。
ウレタンフォーム
 この画像を大きなサイズで見る
この画像を大きなサイズで見るしかもこのキノコ、ゴミ埋立地の底と同じ嫌気性の環境条件でも余裕で生きていられるという。
プラスティック系のゴミ処理問題はコストもかかる上、環境的にも問題視されていたが、もしかしたらこのキノコが埋立地などでプラスティックを分解し、土に還してくれるかもしれないとして期待されているという。
微生物や菌類や植物、あるいはそれらの酵素を用いて有害物質で汚染された自然環境(土壌汚染の状態)を、有害物質を含まない元の状態に戻す、「バイオレメディエーション」は何世紀にも渡り利用されてきた。
近年では、遺伝子工学により微生物を遺伝子操作し、バイオレメディエーションに特に役立つような微生物を作り出すという研究も進められている。
「Deinococcus radiodurans(デイノコッカス・ラディオデュランス)」と呼ばれる、最も放射能耐性の高いバクテリアは、放射能の高い核廃棄物からトルエンや水銀イオンを吸収し消化するように改良されてきたそうだ。
生物はその環境に適応するべく変化していくわけだけど、菌類とか微生物は特にその変化が激しく、予想外の変化を起こしたりもするから、やつらを利用するつもりが実は人類がやつらに支配され、気がついたらうっかり分解されいたなんていうSF的未来とか、想像すると楽しかったり悲しかったり。
追記(2022/07/27)タイトルを一部訂正して再送します。
















うまく利用できるようになるといいね
菌類すごいぞ。。
キノコ食べられないけど、応援する。
こういうのまたアメリカに圧力かけられて潰されるだろ
すげえな
菌類はこれからだからな
自然界ではどうやって生き延びてたんだろ。
ポリウレタンができてから誕生したのかな?
不思議ー。
わかります。
ソファーの皮の下に蒔いたら、菌床ができるのですね。
食えるのか?
偉いキノコやの~、そのうち、働く気も無いニートも喰っちまうようなキノコができるとよいんだけど。
ニート「戦争が起きたらまっさきに戦前に行く」って言う奴いるけど、引きこもって体力も無い活力もないから、そっこうヤラレテ終わり。
>>8
それ以前に訓練におけるシゴキとイジメでバテて精神を病み発狂という、微笑みデブ@ハートマン軍曹コースじゃね?w
>>8
クソニートもろとも、お前のように「ニートじゃないのにもかかわらずクズな人間」も
一緒に分解されればいいのにな。
(こんな時間に書き込んでるが俺はニートじゃないぞ。念のため)
ミジンコなどが合成樹脂類の微粉末を食ったりするそうだが、靴底にもウレタンとか使ってるんだよな。
生物学の研究者などが顕微鏡で見たとき、苦々しい想いをしたりするらしい。
地表付近のだけでも分解されればその分はマシか。
ポリウレタン
http://ja.wikipedia.org/wiki/%E3%83%9D%E3%83%AA%E3%82%A6%E3%83%AC%E3%82%BF%E3%83%B3
「水分による加水分解や空気中の窒素酸化物(NOx)、塩分、紫外線、熱、微生物などの影響で徐々に分解される。分解はその素材が合成された時から始まる。」
元々分解しやすい素材なんだよね。
こういう技術が実用化に至るまでに、いったいどのくらいの時間がかかるのだろうか。
男は、すでに菌類に支配されているようだ、、
だってキノコが1本生えてるじゃないか w(テヘペロッ)
ポリウレタンの分解かぁ、ポリプロピレンの分解だったら喝采ものでしたのにね
でも探せば分解きのこが見つかるかもしれない、それにしても自然って偉大だね
amazon.comでコンポスト用の菌が発売されたのかとおもった
採取した時はグアバの木についてたんだよな?
・・・じゃあ、なんのためにポリウレタン分解能力なんか身につけたんだ??
不思議やでぇ。
アマゾン菌ドルキター
チックじゃないのよティックなの
私の3万円で買ったマットレスも分解されてまうん?
先進国の都市部で大発生したら大笑いだな
アマゾンのキノコでさえ世の役に立つのにお前らのキノコは何の役にも多々ねぇじゃねぇか
昔、地球少女アルジュナというアニメがあってだな・・・
それじゃエネルギーには困らなくなるって事?
ポリウレタン→炭素、じゃ実用性で微妙すぎるでしょ
とっくの昔にどこの焼却所でも焼いて炭素に戻してるんだし、いまさらな変換
アマゾン出のキノコなら全プラスチックを原油へ戻す程度のことはこなしてくれないと
いけすかない奴の家にこっそりこいつの胞子を撒く奴が…
昔、風の谷のナウシカというアニメがあってだな・・・
そのうちキノコが人間にプラスチックを分解させる時代が来る
じゃ俺はこのキノコをバタ焼きにして食ってやる。
食い合いながら生きていく愛の形だ。
醸して醸して醸しまくれー
そうして人類を救うのだ
(*´∀`)アハ
使ってるポリウレタンにこの菌が付いたら、分解して欲しくなくても分解しちゃうんだろうか?
寝床に使ってるマットレスに繁殖したら困るな。(^^;
>ポリウレタンを炭素に分解するキノコ
>土に還してくれるかもしれない
キャンプ場とかで灰になっていない炭を埋めるのが禁止されてるのは、炭素は土に帰らないからなんだけど…